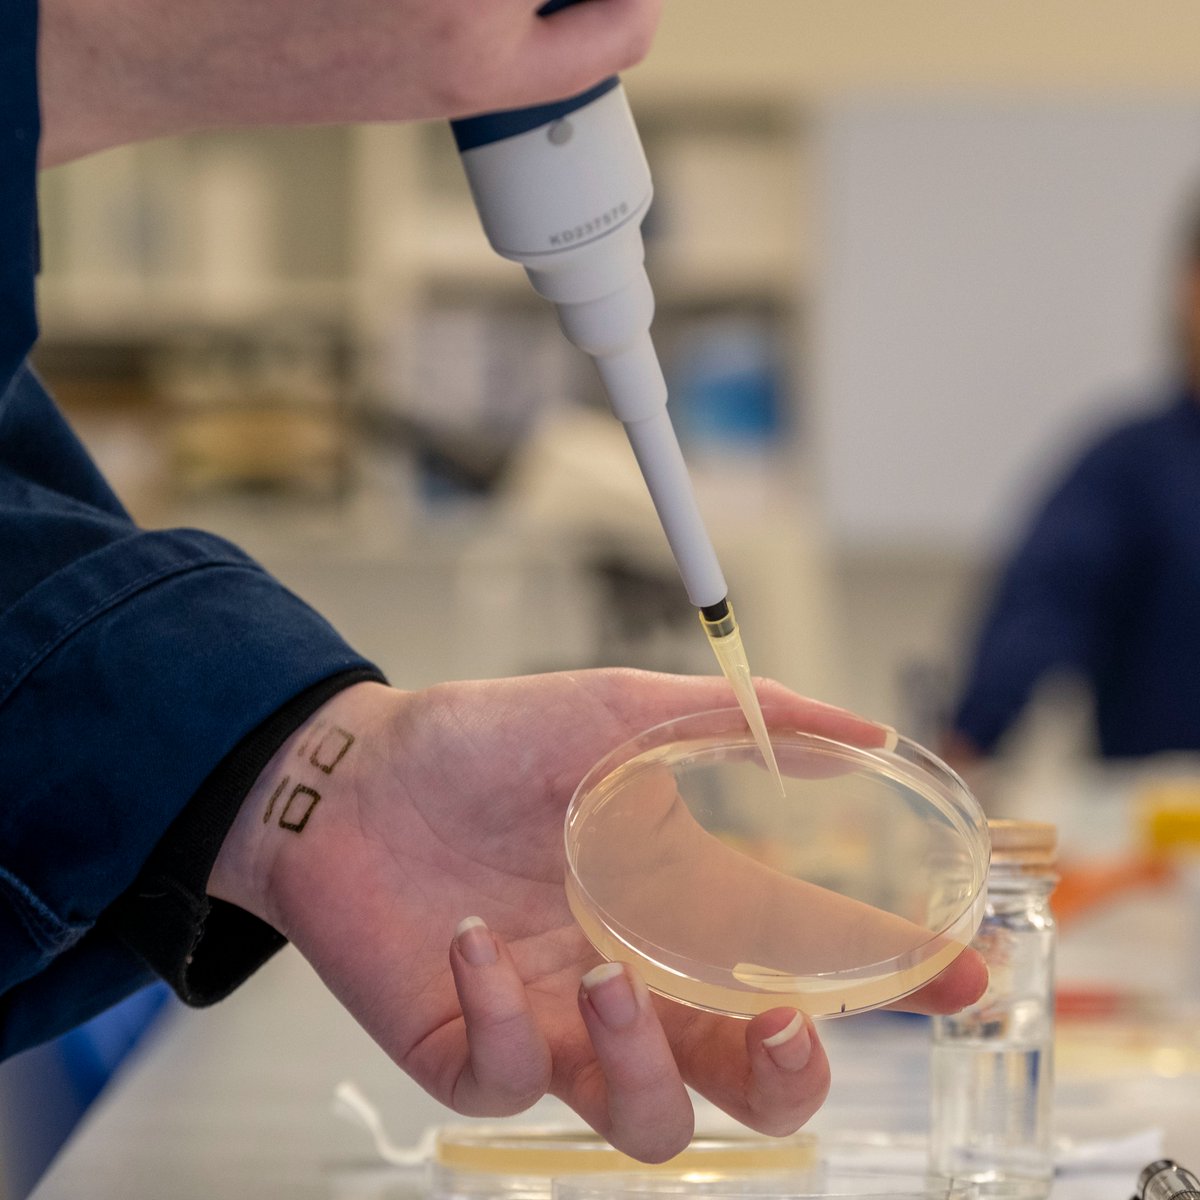
Glasgow_Clyde's tweet image. Thinking of a starting a new career in science for 2025? Take your first steps with our Get into HN Science course starting in January. It could be exactly what you're looking for! Find out more and apply at: bit.ly/3Z8QmQB

#youcan #GlasgowClydeCollege #studyscience

#studyscience search results
Are you interested in developing your understanding of Forensic or Applied Science? Our courses embed skills that are key to progression within science-based industries. To find out more and apply visit bit.ly/3rD8GOB #forensics #studyscience #buckscollegefactor
The good side of having courses available for distance students is that you get students from all over the world. No matter the time zone, if lectures are recorded! #studyscience #opensperspective 🇪🇺🇸🇪🌍📚 @linneuni
#WASoils2019 Applications of soil research knowledge to forensic science and evidence gathering. Rigor, evidence and methods critical. #diversecareers #studyscience @UWA_Science @SAgE_UWA @SoilScienceAust

Ever wondered what it's like to do a year out in industry? Find out about Lydia's placement experience at Cancer ResearchUK here vimeo.com/348407584 #studychemistry #studyscience
[HKU Young Scientist Scheme (YSS) Participants Going to Immerse Themselves in Intellectual Exchanges at Top Universities] Hear what Max Tin said about his forthcoming exchange study at ANU in 2018-19. scifac.hku.hk/yss #YSS #hkuyoungscientistscheme #studyscience
![hku_science's tweet image. [HKU Young Scientist Scheme (YSS) Participants Going to Immerse Themselves in Intellectual Exchanges at Top Universities] Hear what Max Tin said about his forthcoming exchange study at ANU in 2018-19. scifac.hku.hk/yss
#YSS #hkuyoungscientistscheme #studyscience](https://pbs.twimg.com/media/DgnHxA0UEAIclJs.jpg)
![hku_science's tweet image. [HKU Young Scientist Scheme (YSS) Participants Going to Immerse Themselves in Intellectual Exchanges at Top Universities] Hear what Max Tin said about his forthcoming exchange study at ANU in 2018-19. scifac.hku.hk/yss
#YSS #hkuyoungscientistscheme #studyscience](https://pbs.twimg.com/media/DgnHxA2UcAAMgM_.jpg)
Taking an arts degree? Do the maths. Please do read this by Robert Shrimsley in the @FinancialTimes. Very very useful to South Africa: ft.com/content/df7d42… #education #humanitiesDegreesUseless #studyScience
London’s internationally acclaimed @sciencemuseum is set to blow minds across six Cumbrian schools in a temperature plummeting extravaganza.#supercoolshow coming to the county next week @CumbriaUni. #studyscience #findyourplace STORY:ow.ly/Tsx150jK3ZS

Our Centre for National Parks and Protected Areas work closely with the local community on a number of projects. Tackling issues from climate smart forestry to how bugs and veggies can improve our land. Read more: ow.ly/zByS50DQYMK #cumbriauni #BSW21 #studyscience

Make 2022 your year for Sciences at @UniofAdelaide Prior to the Change of Preference Deadline, we’re hosting an online event to answer your questions - this Thursday Jan 6 at 6pm bit.ly/3FUQx5M #UniofAdelaide #NewStudent #StudyScience #ScienceStudents #StudyAdelaide

Interested in a career in Science? Limited places are available on a selection of our courses - find out more and apply at: ow.ly/27vC50Kcivl #youcan #gccbelong #studyscience #studywhatyoulove #careersinscience
Achievement unlocked 🔓 have a professional "in the lab" photo taken of you when intently staring at an object! Very lucky to have my work at the @FertiliserHub spotlighted by @SciMelb! Paper to come soon! (hopefully) #womeninSTEM #ilooklikeascientist #studyscience

We have been lucky to receive an inspiring message from @jimalkhalili #ASACheltenham #Science #StudyScience
About to start an honours project in soil erosion and regeneration of pastoral land? You could be $10K better off with a Ranson Mortlock Scholarship to support your studies - bit.ly/3IJhg6E #Scholarship #HonoursinScience #StudyScience #SoilScience #Erosion #Agriculture

Why study Science? 🤔 Check out the video below ‘Why Science is for me’. This shows how the skills that you learn in your Science lessons can be used in many different careers. 🎮⛹🏻📰📈🧬🩺 youtu.be/wstW5jy_WAU @CaldervaleHigh #studyscience
To kick off British Science week we’re celebrating BOOM. Back On Our Map is a pioneering species reinforcement and reintroduction project. Take a look at our progress here: ow.ly/xOyF50DQtwH #cumbriauni #BSW21 #studyscience

Our Science graduates have progressed to jobs in a diverse range of industries and to further study at degree level at prestigious UK universities; so whatever area of Science you are passionate about, we can help you on your journey. 🔬🧪🥼APPLY NOW: ow.ly/Jb4Y50Paq9g

✨ Curious about life & Earth? At Western University, Biological & Geological Sciences open doors to more than med school! 🌍🔬🪨 Hands-on labs, real research, & endless careers — from medicine to climate solutions. Join #FutureMustangs #WesternU #StudyScience #ClassOf2025

All you have to do is read the daily headlines to understand we live in an interdependent world. 🌏 We must work cliseky together to solve the challenges before us. #StudyScience #StudyHistory #EducationMatters

#TheBigBookOfBlooms🌸 #StudyScience☀️ #Exploration💫 #ReadersAreLeaders📚 #BooksForChildren📚 @yuvalzommer
#homeschooling2021 ‘O’ is for orchids and ‘C’ is for readers’ creativity! #TheBigBookOfBlooms #bigbookskidart #EveryChildIsAnArtist @thamesandhudson


Choosing science isn’t just about becoming a doctor or engineer — it’s about keeping every door open. Let UStudy Global help guide your path. 🌍 📩 DM us to know your best-fit career abroad. #UStudyGlobal #CareerAdvice #StudyScience
Spaced repetition + active recall = powerful retention. These aren’t buzzwords—they work. 🔗 michaeleweintraubesqscholarship.com/how-to-use-act… #StudyScience
michaeleweintraubesqscholarship.com
Master Active Recall for Exam Success
Use active recall and spaced repetition to retain more and ace your exams with less stress and better focus.
How do you actually learn? Hint: It's not from cramming. It's not even by making new brain cells. Real learning happens when your brain rewires itself — by adjusting its neural connections #studyscience #Neurology #Medstudent #studytwt
#StudyScience Ready to take the next step in science? Our Applied Science Level 5 course offers hands-on lab work, simulation models & software training. Progress to Level 6, HNC/HND or degrees. Inspired by Mhari? Apply now for September! 🔬 #UHIinverness #ApplyNow
✨ Curious about life & Earth? At Western University, Biological & Geological Sciences open doors to more than med school! 🌍🔬🪨 Hands-on labs, real research, & endless careers — from medicine to climate solutions. Join #FutureMustangs #WesternU #StudyScience #ClassOf2025

Those who #StudyScience KNOW! Our #HeroHotez #MicrobeHunter #VaccineWarrior fighting to bring protection to ALL by developing UNPATENTED NONPROFIT his #VaccinesSaveLives! ALL OVER THE WORLD! 🌎 Educating about how #DisinformationKills #ScienceMatters #PublicHealthMatters

Join us at the Nelson Mandela University in Door Sports Centre for Open Day from 16–17 May 2025! The Faculty of Science is here to inspire, engage, and answer all your questions about a future in science. Don’t miss out! #NMUOpenDay #FacultyOfScience #StudyScience




Nuclear Radiation : Alpha, Beta, Gamma & More—All in One Visual! youtu.be/faqCMn6jrCU #StudyScience #PhysicsInfographic

🎓Admission Open for B.Sc. Courses!🌟 Looking to build a strong foundation for your future? Enroll in . programs and take a step toward a successful career in Science & Technology!✅ #BScAdmission #BrilliaantCareerSolution #StudyScience

🎓✨ Build Your Future with a B.Sc. Degree! ✨🎓 📢 Admissions Open for . Courses! 🚀 #BScAdmissions #StudyScience #ScienceDegree #HigherEducation #CareerInScience #BScCourses #EducationMatters #FutureReady #BrilliaantCareerSolution

Thinking of a starting a new career in science for 2025? Take your first steps with our Get into HN Science course starting in January. It could be exactly what you're looking for! Find out more and apply at: bit.ly/3Z8QmQB #youcan #GlasgowClydeCollege #studyscience

Thinking of a starting a new career in science for 2025? Take your first steps with our Get into HN Science course starting in January. It could be exactly what you're looking for! Find out more and apply at: bit.ly/3Z8QmQB #youcan #GlasgowClydeCollege #studyscience

Get to know the key components of this vital organ, one beat at a time. ❤ #HeartAnatomy #BiologyLabels #StudyScience Contact us through: ▪ DM at @tutors.pro ▪ Call/text at (917) 969-1194 ▪ [email protected] ▪ tutorspro.com
Want to learn Math with 3D models? Get Saras-3D app to propel your Mathematics, Physics, Chemistry and Biology studies to new heights! And the best part? It’s completely FREE to get started. No payment details required. #LinkinBio #Saras3D #StudyScience #Science #LearnScience
This year we have 3 scholarships available in any relevant area of physics & astronomy, and 1 scholarship available in nanophotonics for quantum control, interstellar travel & passive cooling. Applications close 26 June. Learn more: tinyurl.com/72ykjyju #PhDchat #studyscience

Achievement unlocked 🔓 have a professional "in the lab" photo taken of you when intently staring at an object! Very lucky to have my work at the @FertiliserHub spotlighted by @SciMelb! Paper to come soon! (hopefully) #womeninSTEM #ilooklikeascientist #studyscience

Congratulations to Cassandra Fernandes for reaching the national finals in the @worldskillsuk 2023 Laboratory Technician competition! Interested in studying Science? Head to our website to book your Open Event tickets now! #WorldSkillsCompetition #ScienceCourse #StudyScience

#WASoils2019 Applications of soil research knowledge to forensic science and evidence gathering. Rigor, evidence and methods critical. #diversecareers #studyscience @UWA_Science @SAgE_UWA @SoilScienceAust

✨ Curious about life & Earth? At Western University, Biological & Geological Sciences open doors to more than med school! 🌍🔬🪨 Hands-on labs, real research, & endless careers — from medicine to climate solutions. Join #FutureMustangs #WesternU #StudyScience #ClassOf2025

Have a look at these 10 study habits #learning #studyscience content.sylvanlearning.com/blog/wp-conten…

Congratulations to Cassandra Fernandes for reaching the national finals in the @worldskillsuk 2023 Laboratory Technician competition! Interested in studying Science? Head to our website to book your Open Event tickets now! #WorldSkillsCompetition #ScienceCourse #StudyScience

Our Centre for National Parks and Protected Areas work closely with the local community on a number of projects. Tackling issues from climate smart forestry to how bugs and veggies can improve our land. Read more: ow.ly/zByS50DQYMK #cumbriauni #BSW21 #studyscience

Your Anti-dote to get you through in Any Exam. Works 100% Download Now 👇 play.google.com/store/apps/det… #studygram #studyscience #studystation #jeemain2021exam #neetonlinecoaching #neet2021 #aspiringstudents #RailwayTestSeries #railwayexampreparation #bankingexamspreparation #elearning

This Fall 2019, explore BIO 105 - 1 The Organization and Diversity of Life! This course studies biological concepts and mechanisms using current examples from medicine and the environment. 🌿 #StudyScience #BIO Find out more OR apply by clicking here: bit.ly/30FmsSV

[HKU Young Scientist Scheme (YSS) Participants Going to Immerse Themselves in Intellectual Exchanges at Top Universities] Hear what Max Tin said about his forthcoming exchange study at ANU in 2018-19. scifac.hku.hk/yss #YSS #hkuyoungscientistscheme #studyscience
![hku_science's tweet image. [HKU Young Scientist Scheme (YSS) Participants Going to Immerse Themselves in Intellectual Exchanges at Top Universities] Hear what Max Tin said about his forthcoming exchange study at ANU in 2018-19. scifac.hku.hk/yss
#YSS #hkuyoungscientistscheme #studyscience](https://pbs.twimg.com/media/DgnHxA0UEAIclJs.jpg)
![hku_science's tweet image. [HKU Young Scientist Scheme (YSS) Participants Going to Immerse Themselves in Intellectual Exchanges at Top Universities] Hear what Max Tin said about his forthcoming exchange study at ANU in 2018-19. scifac.hku.hk/yss
#YSS #hkuyoungscientistscheme #studyscience](https://pbs.twimg.com/media/DgnHxA2UcAAMgM_.jpg)
All you have to do is read the daily headlines to understand we live in an interdependent world. 🌏 We must work cliseky together to solve the challenges before us. #StudyScience #StudyHistory #EducationMatters

Love cool #Hokie stuff? 🧡🦃 Look no further. Register for our virtual 3.14 #PiDay 5K event and all this can be yours: shirt, sticker, and beanie. Register by Monday, Feb. 21, to ensure you get all these goods by March 14.science.vt.edu/get-involved/e… #StudyScience #DoScience

Achievement unlocked 🔓 have a professional "in the lab" photo taken of you when intently staring at an object! Very lucky to have my work at the @FertiliserHub spotlighted by @SciMelb! Paper to come soon! (hopefully) #womeninSTEM #ilooklikeascientist #studyscience

Prepare for a career not just a job at the College of Science, Oregon State University. Learn more. bit.ly/2SWfGo8 #graduate #studyscience

Thanks to Ben from @StrathChem who came to talk to S2 to S5 pupils today about subject choices and the many career paths relating to chemistry. We learned that gold nanoparticles make covid lateral flows change colour! #dyw #careers #StudyScience @TurnbullHS @StemTurnbull

Congratulations to our biomedical science graduate Kate Secombe, who won the @UniofAdelaide STEM Award at last week’s Young Achiever Awards ceremony #CareersinSTEM #ScienceAlumni #StudyScience #youngachiever #youngachieverawards #southaustralia #sayaa #sayouth @EngagewithUoA

Did you know 🧠💡 Electrons don't move through the space while charging their energy levels. Instead, they disappear from one level and reappear on another level! #studyscience #studywith #science #phisics #student #study #revise #revisiontips #tuesday #didyouknow #dyk

Want to #studyscience at Birkbeck + keen to start autumn 2018? You can apply through #Clearing – call us 02039070700 + come to our next #BirkbeckOE on Wed 5 Sept ow.ly/dH0u50ijsLe

Something went wrong.
Something went wrong.
United States Trends
- 1. #MerloFC N/A
- 2. #NIKKETTStar N/A
- 3. #NIKKEAnniversary N/A
- 4. Good Saturday N/A
- 5. #LoveYouTeacherSeriesEP6 N/A
- 6. #sabchella N/A
- 7. SB19 TrilogyConcert Finale N/A
- 8. Seek the Lord N/A
- 9. Madonna N/A
- 10. Jalen Green N/A
- 11. Whale - Buy N/A
- 12. Steph N/A
- 13. Warriors N/A
- 14. The Atlantic N/A
- 15. Steve Kerr N/A
- 16. AJ Styles N/A
- 17. Suns N/A
- 18. Like a Prayer N/A
- 19. Draymond N/A
- 20. Scott Foster N/A



























































